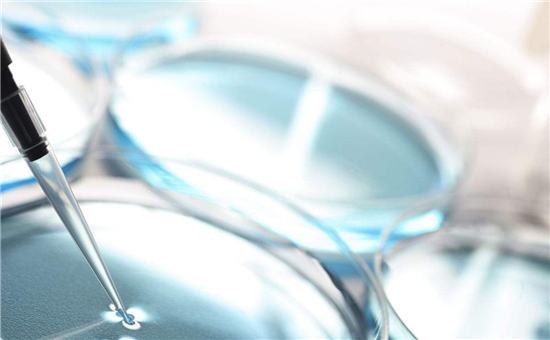
记录一次电池负极混料异常 记录一次电池负极混料异常

今天,分享一次在实验室实际试验工作中的混料异常以及最终的解决措施,以下具体问题的分析和总结不对的地方,欢迎大家批评指正,并分享思路和想法。
首先,简单介绍下实验室基本情况。本人所在实验室使用传统的双行星搅拌机,有效容积为10L,浆料制备完成后,测量粘度,然后用150目筛子手动过滤浆料,使用逗号辊转移涂布机进行涂布。
石墨负极浆料制备基本过程为:
(1)首先采用双行星搅拌机将CMC高速分散溶解在去离子水中,CMC浓度约1.5%,溶解时间大概3-4h。
(2)在已经制备的胶液中加入导电剂,开启搅拌,先慢速后高速,时间约30-60min。
(3)负极材料分两次加入,先慢速搅拌15min,刮边后,持续搅拌2-3h
(4)加入适量的水稀释浆料,粘度调节到2000-5000cP。
(5)加入SBR溶液,搅拌1-2h,后慢速搅拌真空脱泡。
我们之前使用JSR(日本合成橡胶公司)的TRD2001型SBR粘结剂,厂家推荐应用于D50大于15um的锂离子电池,JSR厂家说明的SBR特征为:(1)通过表面官能团的控制优化了SBR表面性能,提高了在电解液中的稳定性和在浆料中的稳定性;(2)通过复合技术,增强了活性物质与基材之间的粘结性;(3)通过良好的颗粒粒径控制技术,增加了活性物质之间的点接触并增强了活性物质之间的粘结性;(4)通过良好的高弹性控制技术,使SBR能够满足更多次充放电过程中的膨胀收缩。按照以上所述搅拌工艺制备浆料。
后来,更换了国内某家的SBR之后,仍旧按照该工艺进行浆料搅拌,浆料出现了问题:浆料特别容易沉降,在过滤时很快堵塞筛网,根本无法过滤,锅底明显存在结团硬块,如图1所示。第一次浆料粘度5000cP出现这种情况,后续几次加水稀释将浆料粘度调节至2000cP,问题仍旧存在。

图1 异常浆料
经过系列实验和分析,搅拌工艺调整如下:加入SBR溶液后,搅拌时间由1-2h延长至3h以上,其他条件和步骤完全没有改变。沉降结团问题解决,正常浆料如图2所示,此时浆料不存在结团硬块,也能够顺利过滤。

图2 正常浆料
补充知识点:
(1)CMC-Na是一种线性高分子离子型纤维素醚,全名叫羧甲基纤维素钠,在CMC分子上既含有未经过羧基改性的疏水主链,又含有经过羧基改性的亲水主链,在一定浓度的水性石墨负极浆料中,CMC中疏水性的主链通过吸附包覆在石墨、导电剂等表面疏水性的颗粒表面,吸附的CMC分子之间的相互斥力使石墨颗粒分散均匀;同时亲水性又能使其悬浮在水溶液中,起到分散和稳定作用。CMC产品水溶液的溶解性、黏度及与石墨的亲和性受其分子量、取代度浓度及pH等参数影响。其中分子量和取代度等结构参数决定了石墨颗粒表面上CMC的吸附量。分子量较大、取代度较高的CMC具有较高的黏度和好的溶解性,更容易吸附和完全包覆在石墨颗粒表面,从而使负极浆料具有较好的稳定性和涂布特性。
(2)SBR是一种丁苯胶乳,水性粘结剂,SBR是一种是一个亲水性和亲油性共存的物质。水性基团与箔材表面基团结合形成粘结力,有利于分散性和浆料稳定性;油性链段与负极石墨相结合形成粘结力,从而达到粘结的效果
(3)目前,在商业化的锂离子电池生产中,负极普遍使用羧甲基纤维素钠(CMC)和丁苯橡胶(SBR)等水溶性黏结剂。sbr没有分散功能,单独使用sbr作为粘接剂,因为很难制备浆料,同时太多的sbr也会使得极片在电解液中溶胀。使用CMC的一个作用就是作为分散剂,分散石墨和导电添加剂。CMC在水中会形成凝胶,使得浆料变稠,既能保水份又能稳定浆料;CMC粘结性差,并且是刚性材料,单独使用时辊压后特别容易断裂掉粉。而引入SBR,其本身是柔性材料,具有较好的粘接性能,高压实下极片更不容易掉粉,极片粘接强度也高。


- 最新评论
- 我的评论
